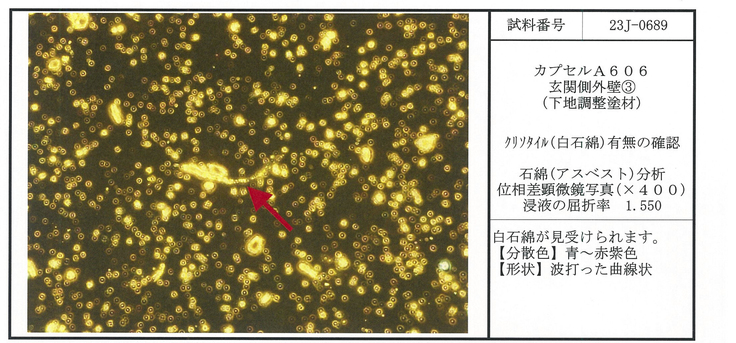

支援総額
目標金額 3,000,000円
- 支援者
- 188人
- 募集終了日
- 2022年11月25日
カプセルの外壁には許容値の31倍のアスベストが含有されていました

2023年9月25日の新着情報「カプセル外壁のアスベスト再調査のため検体採取を行いました」から少し時間が経ちましたが、カプセルA606外壁のアスベスト分析調査の結果をご報告します。
結論からお伝えすると、残念ながら、
カプセルの外壁には許容値の最大31倍の石綿(アスベスト)が含有されていました。さらに、過去に再塗装されていた箇所も含め、外壁全てに石綿(アスベスト)があることが分かりました。
労働安全衛生法施行令 第16条では、石綿(アスベスト)の許容値は重量0.1%未満です。今回行った2023年9月の分析調査で、カプセル外壁には最大3.1%の石綿(アスベスト)が含有されていることが分かりました。
私たちに、カプセルの状態について問い合わせを頂くことが多数あるため、公衆衛生の観点から記載します。
残念ながら、現状のカプセルは、外壁に基準値の31倍のアスベストを、内部には飛散性の極めて高い茶石綿(アモサイト)の吹付アスベストが残留していることは理解した上で、利用・所有を判断されると良いのではと思います。ただし、現行法規では重量0.1%を超えるアスベストが含まれる物は譲渡も禁止されています。
ここから詳しく記載します。
今回の分析結果で、「白石綿」と呼ばれ建材に多く使用されていた「クリソタイル」という石綿(アスベスト)が外壁の塗料にあることが分かりました。
下記が分析結果の報告書で、赤い四角で囲った箇所で、「クリソタイル」の項目が「含有」となっていて「重量%」が記されているのが分かると思います。カプセルから採取した1、2、3の検体に対しての分析結果が2枚に分かれて記載されています。
ちなみに、内部に残留する吹付アスベストは「茶石綿」と呼ばれる「アモサイト」という石綿(アスベスト)が使用されていました。「茶石綿」は「含有せず」とあり、採取時に混入していないことも分析結果から分かります。
<外壁3の報告書>

<外壁1+2の報告書>
含有していた白石綿は下記のような姿をしていました。この細長い鉱物が肺に刺さり、肺がん・中皮腫・石綿肺などの病気を引き起こし、人の健康を害します。

ところで、現在の日本では、石綿(アスベスト)重量0.1%を超えて含有する全ての物については、製造・輸入・譲渡・提供・使用が禁止されています。
下記は厚生労働省が配布する、平成18年(2006年)にアスベストが全面禁止されていることを示す資料です。


例外的に「平成18年9月1日において現に使用されている物については、同日以降引き続き使用されている間」は適用しないという適用除外があります。
ですが、
東京都中央区銀座の地で建物としてはすでに解体され、全く別の場所に運ばれたカプセルについては「引き続き使用されている」状態にはならず、適用除外には当たらないだろう
というのは、問い合わせた複数の労働基準監督署の判断でした。
当たり前の解釈だと思います。本来、労働者や周辺の住民や物の使用者などを健康被害から守るため、安全側に考えるのが当たり前です。「現に使用されている物」なども、過去においては適法だったものが後になって違法状態になったものについての適用除外のため、それを都合良く解釈する訳にはいきません。
2020年後半から、
世間を騒がせたアスベスト入り珪藻土のバスマットは含有率0.2〜1.5%で、最大販売数のメーカー「ニトリ」だけでも355万個の商品回収などが行われました。
参照:ニトリ販売のバスマットから基準15倍のアスベスト検出(2021年1月6日、アジアプレスネットワーク)
今回、私たちが行ったアスベストの分析調査の結果をもう少し詳しくみていきます。
最初にもふれました、2023年9月25日の新着情報「カプセル外壁のアスベスト再調査のため検体採取を行いました」に分析箇所なども詳しく書いていますが、簡単に記載します。
今回、外壁を採取したのは赤丸で囲った3箇所です。左から外壁1番、2番、3番とナンバリングしました。

1番と2番については砂壁状で、図面にも記載があったアスベストが含まれる砂壁状の吹付塗料「ケニテックス」が残っているのではないかと考えていたのですが、今回の分析結果で白石綿が重量1.8%ある物質だと分かりました。つまり、「ケニテックス」が残っていたということです。
また、3番については、外側からもよく見える位置で、パッと見はきれいになっているところです。道路側などに面する外壁は、昭和60年(1985年)に建物全体で行われた外壁補修時の樹脂製と思われる塗料が塗られています。2015年に一部のオーナーたちによって防水工事も行われましたが、その年代ではアスベストを含有するものは使用できません。
今回の分析調査では、1番と2番はほとんどが薄い塗膜ということで、それ単体で分析してもらいました。
3番については、上の塗料・主材と下の下地調整塗材で分けて詳細な分析をしてもらいました。3番では、下地調整塗材と呼ばれるものに重量3.1%のアスベストが検出されました。つまり、竣工時からある「ケニテックス」が残っているということです。

カプセルA606を譲り受けたタイミングで、1番・2番は劣化して「ケニテックス」がすでに無い場所も多かったです。画像はカプセルA606を取り外す際の動画から切り出したもので、手前に見えている壁面は隣のカプセルとの間に隠れていましたが、壁が劣化しているのが分かります。

逆に、上から樹脂製の塗料を塗っているところは下にしっかりと「ケニテックス」が残ってしまっている状況でした。
中銀カプセルタワービル管理組合法人がアスベストの分析調査した2017年は、仕上塗材の下地を含めて分析をすることがまだ少ない時期だったため、表面の塗材だけ分析して「アスベスト含有なし」という結果を出していたのではないかと思います。
現在は、アスベストに対する法律が厳しくなっており、仕上塗材については下地材まで分析するのが基本的な考え方です。今回、そのやり方で採取・分析したところ、大変残念ながら、新しそうな仕上げ面にすらアスベストが残っていることが分かりました。
私たちとしては、今後、50年後まではカプセルを使用したいと考えているため、他の6カプセルについても「みなし含有」として、カプセルの外壁塗料もアスベストがあるとして全除去します。
「当時の塗料や仕上げに価値がある、残すべき」という考え方もあるとは思います。ですが、私たちは長く建築として使用したいと考えているので、安心・安全に使用できるように、外壁の塗料の全除去、そして、カプセル内に残る吹付アスベストの再除去を行います。
カプセル内の吹付アスベストは外壁を外さないと完全には除去できません。外壁にもアスベストがあるため、まずは外壁のアスベスト除去作業から行わないといけません。
2023年に外壁のつくりを知るため、2022年12月からカプセルの外壁を取り外す作業を行ってきました。
2022年12月4日新着情報「カプセルA606の外壁パネルを外しました!」
2017年のアスベストの調査結果をもとに、あからさまに古そうな外壁の箇所はふれないようにしていました。新しい外壁箇所にはアスベストが無いと考えていましたが、私たちは外壁を外す作業の際は念のため湿潤をしてから行っていました。途中からはアスベスト用の保護マスクをして取り組んでいました。
なお、2023年1月に「石綿含有建材調査者」の資格を取得し、すぐに調査を行いたいと考えてました。
2023年3月2日新着情報「アスベスト再除去の必要性と資格取得」
ところが、分析調査が9月まで延びてしまったのは、「カプセル外壁の分析調査を遅らせてほしい」ととある方から連絡があったためです。
現在、私たち中銀カプセルタワービルA606プロジェクトとは関係の無い別団体により、他の複数のカプセルが展示されたり、移動したりしているようです。
2023年11月8日
中銀カプセルタワービルA606プロジェクト 代表いしまるあきこ
リターン
3,000円+システム利用料

A606プロジェクト応援A(お気持ちのみ)
記念品などをお届けしないかわりに、いただくご支援をできるだけ多くプロジェクトのために使用させていただく コースです。
ーーーーーーーーーー
●御礼のメール
- 申込数
- 23
- 在庫数
- 制限なし
- 発送完了予定月
- 2022年12月
5,000円+システム利用料

カプセルA606+共用部のオンライン見学会ご招待(2022年3月末の解体直前の記録映像より)
●御礼のメール
●カプセルA606+共用部オンライン見学会(期間限定アーカイブ有)
・共用部は1階外部・ロビー・6階ブリッジ・階段室です。
代表いしまるあきこが、解体直前の2022年3月末に、みなさまをカプセルA606へご案内する動画を撮影しました 。
当時、現地開催を検討していましたが、裏の増築部の解体が始まっていたことによる粉じんやアスベストの影響を鑑み、実施を断念しました。そのため、映像で記録を残しました。
2022年3月末にはA606室内にベッド・スツールなどもフルレストア(復元)していたため、その解説もしています 。
今回の映像は前回のクラウドファンディングのリターンとして2021年8月に実施したオンライン見学会とかぶる内容もありますが、より細かな内容でお伝えし、雰囲気も変わる予定です。
撮影日:2022年3月31日
撮影・編集:和久井幸一
企画:いしまるあきこ
※2023年1月末までに開催予定、日程などの詳細を追ってご案内いたします。
- 申込数
- 22
- 在庫数
- 制限なし
- 発送完了予定月
- 2023年1月
3,000円+システム利用料

A606プロジェクト応援A(お気持ちのみ)
記念品などをお届けしないかわりに、いただくご支援をできるだけ多くプロジェクトのために使用させていただく コースです。
ーーーーーーーーーー
●御礼のメール
- 申込数
- 23
- 在庫数
- 制限なし
- 発送完了予定月
- 2022年12月
5,000円+システム利用料

カプセルA606+共用部のオンライン見学会ご招待(2022年3月末の解体直前の記録映像より)
●御礼のメール
●カプセルA606+共用部オンライン見学会(期間限定アーカイブ有)
・共用部は1階外部・ロビー・6階ブリッジ・階段室です。
代表いしまるあきこが、解体直前の2022年3月末に、みなさまをカプセルA606へご案内する動画を撮影しました 。
当時、現地開催を検討していましたが、裏の増築部の解体が始まっていたことによる粉じんやアスベストの影響を鑑み、実施を断念しました。そのため、映像で記録を残しました。
2022年3月末にはA606室内にベッド・スツールなどもフルレストア(復元)していたため、その解説もしています 。
今回の映像は前回のクラウドファンディングのリターンとして2021年8月に実施したオンライン見学会とかぶる内容もありますが、より細かな内容でお伝えし、雰囲気も変わる予定です。
撮影日:2022年3月31日
撮影・編集:和久井幸一
企画:いしまるあきこ
※2023年1月末までに開催予定、日程などの詳細を追ってご案内いたします。
- 申込数
- 22
- 在庫数
- 制限なし
- 発送完了予定月
- 2023年1月

ぬるぬるのお引越|万博・落合陽一 null²パビリオン次なる場所へ
#ものづくり
- 現在
- 217,860,000円
- 支援者
- 12,389人
- 残り
- 29日

タイのDD51北斗星色を守り、綺麗な姿で新天地での活躍を見たい
- 現在
- 585,000円
- 支援者
- 74人
- 残り
- 8日

緊急支援|フィリピン地震へのご支援を
- 現在
- 1,628,000円
- 寄付者
- 222人
- 残り
- 10日

絶滅の危機に瀕しているシマアオジ 彼らのいる景色を取り戻したい
#国際協力
- 現在
- 4,328,900円
- 寄付者
- 370人
- 残り
- 3時間

【緊急支援|大分市 大規模火災へのご支援を】
#医療・福祉
- 現在
- 3,727,000円
- 寄付者
- 444人
- 残り
- 41日

緊急支援|被災重なるフィリピン、台風25号被害へのご支援を
- 現在
- 571,000円
- 寄付者
- 65人
- 残り
- 36日

東京国立博物館|価値ある文化財を救い出す。源氏物語図屏風、修理へ
#伝統文化
- 現在
- 61,815,000円
- 寄付者
- 2,863人
- 残り
- 29日

岩手県越喜来にある不思議な建物「潮目」の写真集をつくりたい!
- 支援総額
- 858,000円
- 支援者
- 66人
- 終了日
- 5/5

悲願!創部26年目に初の全国大会へ!埼玉県の少年野球チームです!
- 支援総額
- 99,000円
- 支援者
- 11人
- 終了日
- 8/20

【第2弾】僕らの夏休みProject~とびきりの夏休みをプレゼント~
- 支援総額
- 700,000円
- 支援者
- 75人
- 終了日
- 8/4
里山キュイジーヌの実現【里山×料理】里山を感じる料理の提案と創造
- 寄付総額
- 850,000円
- 寄付者
- 33人
- 終了日
- 10/31
伊吹の薬草イブキジャコウソウを使った新スキンケア商品を開発!
- 支援総額
- 36,300円
- 支援者
- 10人
- 終了日
- 2/13

奥久谷から窪野へ!ホタル舞う鎮守の杜のコンサートを開催へ
- 支援総額
- 692,000円
- 支援者
- 82人
- 終了日
- 5/29

「福井で70年続く映画館で演劇を」メトロ劇場の魅力を若者に届ける
- 支援総額
- 954,000円
- 支援者
- 71人
- 終了日
- 7/30









